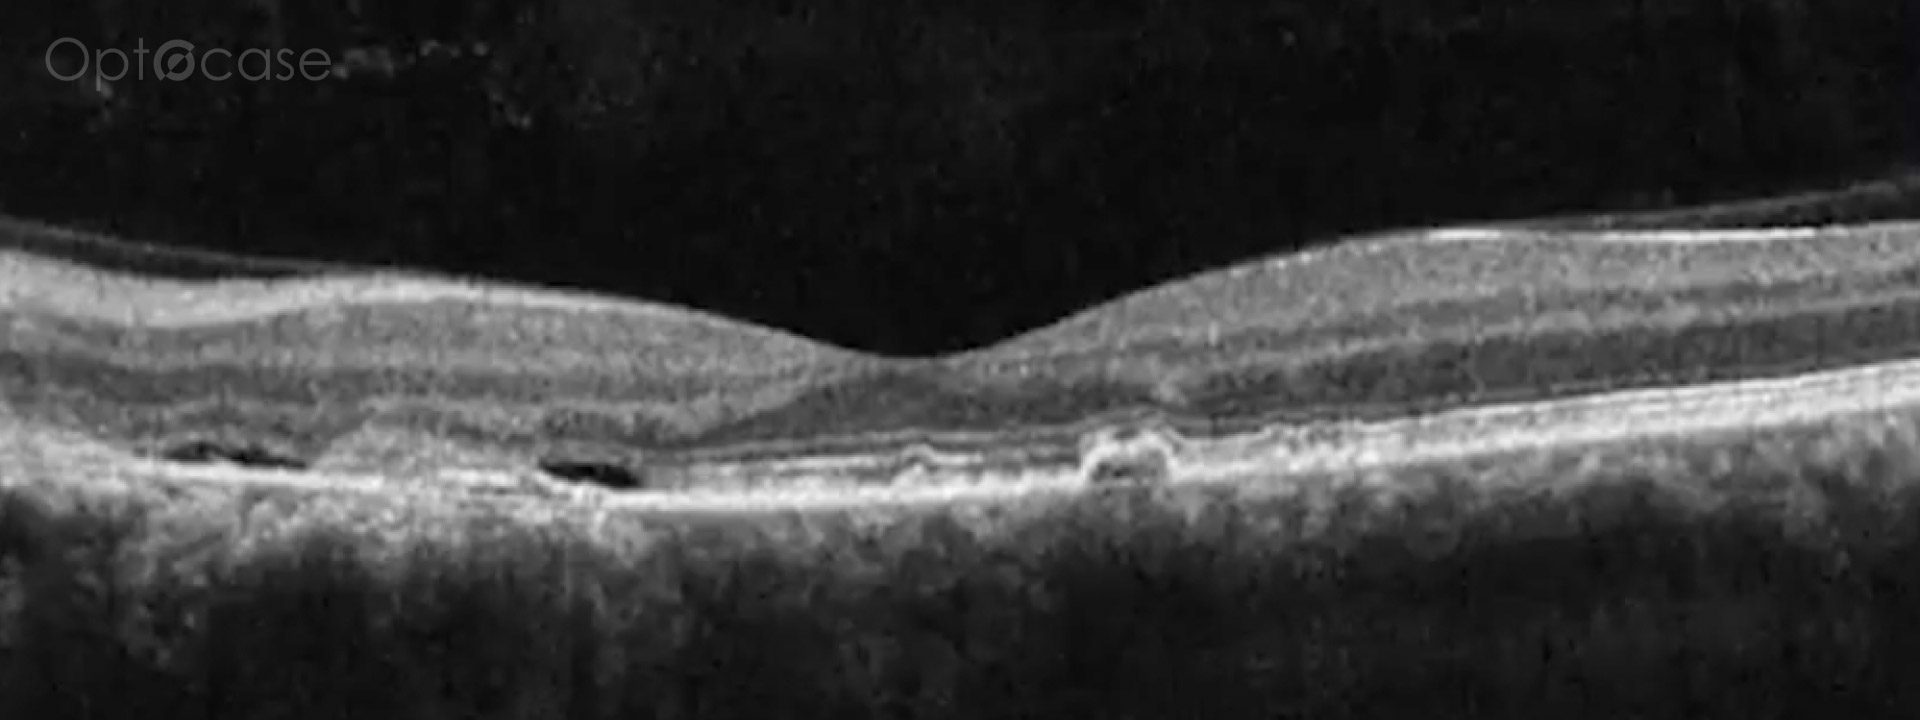
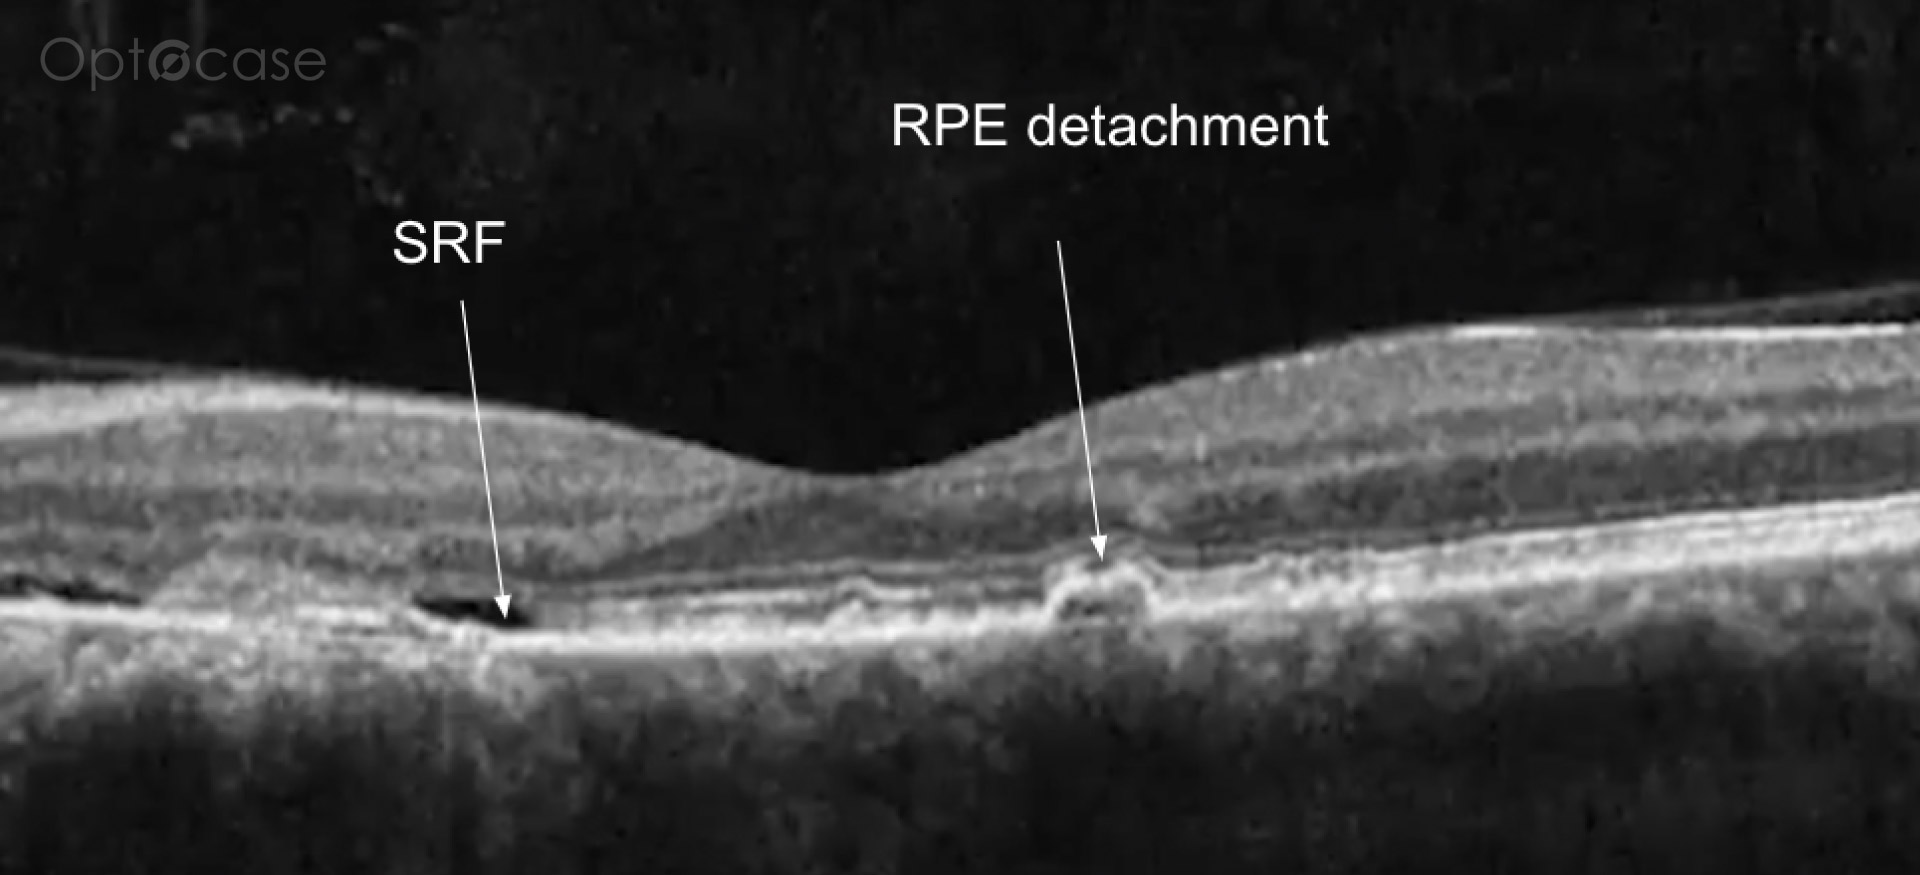

This 49 year-old patient had vertical diplopia for 2 years but normal extraocular movements. They were previously treated for a retinal condition with photodynamic therapy. Why do they have double vision?
Analysis
This patient presented with vertical diplopia, normal visual acuity, no afferent pupillary defect, and full extraocular movements. He was unable to fuse Maddox rod lines with prisms except for transient fusion at distance with prisms. His OCT was normal on the right eye, but showed evidence of a past central serous retinopathy (CSR) treated with photodynamic therapy.
The patient was diagnosed with dragged-fovea diplopia syndrome.
In the video discussion, Dr. Paul Freund will
- Review causes of double vision with normal extraocular motility
- Review the physiological cause of "dragged-fovea syndrome"
- Review how to confirm the diagnosis of dragged-fovea syndrome as the cause of diplopia
Neuro Coach Tip
In a patient with a previous maculopathy, who now presents with diplopia, rule out the possibility of dragged-fovea diplopia syndrome.
Not receiving our tips yet? Subscribe to receive them straight to your inbox.